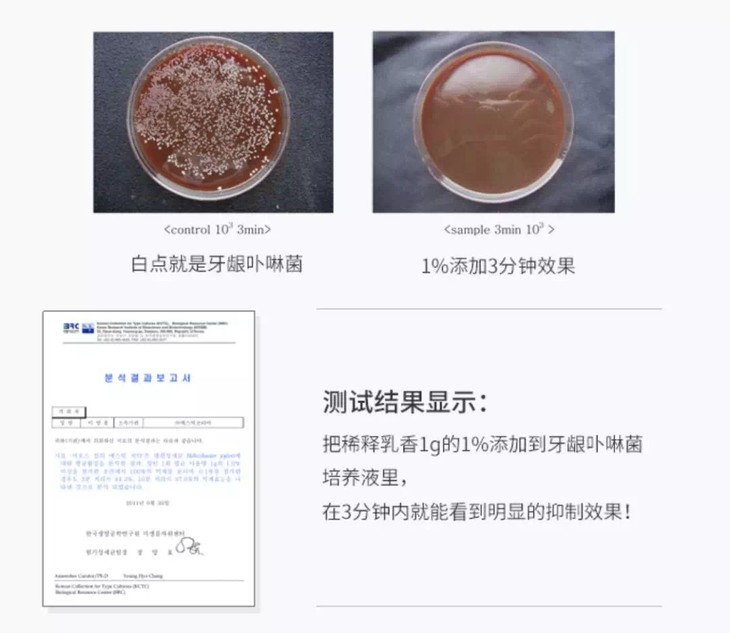

牙膏中的“黄金”,来自希腊的乳香,帮助宝贝清新口气,预防胃病
2019年07月15日
父母常常想对孩子表达爱意,可常常因为一些“重口味”的问题开不了口。
其实这些尴尬的现象都是由口腔细菌引起的。
这些细菌会伴随饮食进入胃中,轻则引发口气,重则染上疾病。而在口腔细菌中幽门螺杆菌的危害性特别巨大,是一种连人体内的胃酸都拿它没有办法的细菌。
麦斯特凯斯乳香牙膏拥有“双重国籍”,韩国医疗团队研发打造,抑制幽门螺杆菌的原料来自于希腊。
每一支麦斯特凯斯乳香牙膏均含有2%的乳香成分(儿童含3%),而这些乳香甄选自希腊爱琴海的希俄斯岛。
每一滴希俄斯乳香都是从岛上的乳香树提取出来,1棵树一年只分泌约100g乳香胶,100g乳香胶仅能提取1g希俄斯乳香油。
一支麦斯特凯斯牙膏所含的乳香,相当于两棵树一年的产出,简直就是牙膏中的黄金。
和一些牙膏成分中常见的中药乳香相比,从质地到药效,希俄斯乳香都更胜一筹。
对于幽门螺杆菌的抑制效果,希俄斯乳香有口皆碑,获得了国内外的广泛认可。
新英格兰时报1998年12月24日发表文章,证实希俄斯乳香对幽门螺杆菌有抑制作用。
添加了希俄斯乳香的麦斯特凯斯牙膏,对于幽门螺杆菌的打击简直就是“希腊神话”般的存在,上市至今载誉无数,使用过的人们都给出了积极反馈。
除了对幽门螺杆菌实施针对性打击,麦斯特凯斯乳香牙膏同样拥有优秀的美白和清新口气功效。
而希俄斯乳香对于口腔中的其它细菌同样有抑制功效,并且预防多种牙龈疾病和口腔炎症。
在美白方面,麦斯特凯斯乳香牙膏充分发挥牙刷的威力,加入了与牙齿成分相同的羟基磷灰石(HAP)粒子。
不含氟化物、防腐剂、调味剂、重金属等有害物质,温和不怕吞咽,孕妇、儿童、哺乳期女性等特殊人群也可以使用,全家人用都可以放心。
590阅读
12赞
凯叔精选